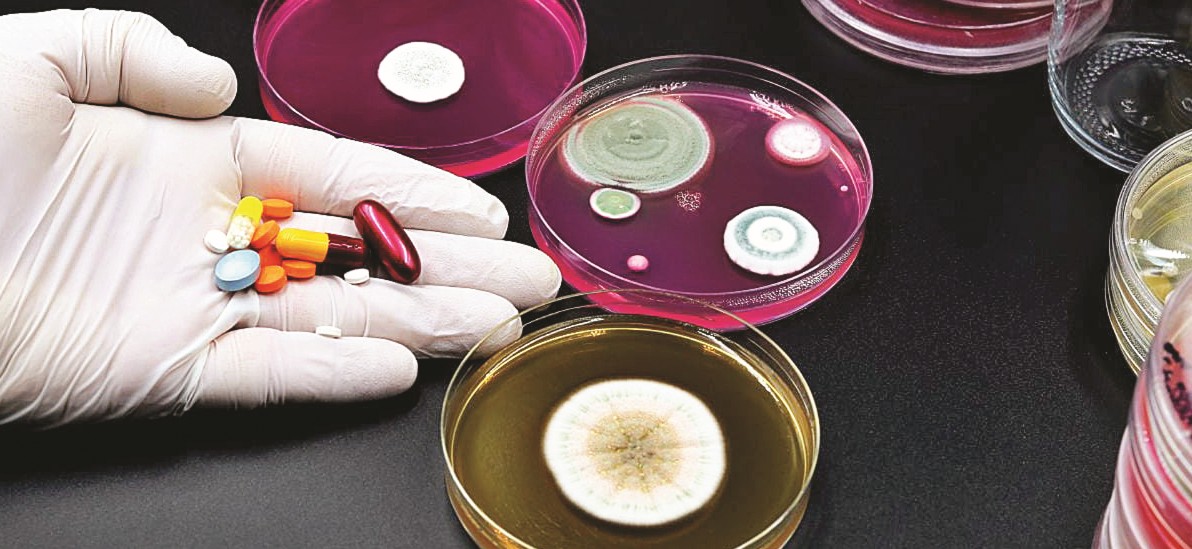

News

Employee wins Rs. 50,000/- compensation from EPFO for 10-year delay in processing EPF transfer claim

Economic Survey Projects India to Remain the Fastest-Growing Major Economy Despite Global Challenges

Piyush Goyal Announces Duty Relief on Harley-Davidson Imports; 3000cc Cars to Become More Affordable

India Emerges as a Leading Contender to Become One of the World’s Top Three Digital Tech Powerhouses

Delhi High Court to Get Three New Judges; Appointments Cleared for Multiple High Courts Across India